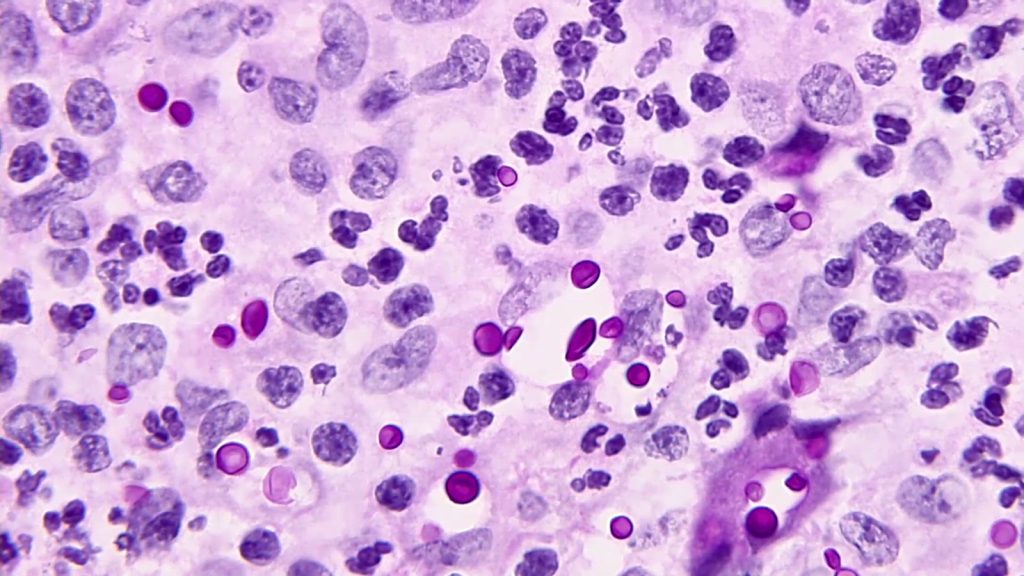
Νέα μελέτη: Ο μύκητας Cryptococcus neoformans αναπτύσσει αντοχή στα αντιμυκητιακά φάρμακα

ΣΥΜΒΑΙΝΕΙ ΤΩΡΑ
-
Κένταλ Τζένερ-Τζέικομπ Ελόρντι: Η πρώτη κοινή τους φωτογραφία σε εστιατόριο που επιβεβαιώνει την σχέση τους
-
Δ.Σταρόβας: «Μεγάλωσα χωρίς πατέρα – Η μητέρα μου έκανε τρεις δουλειές για να μας συντηρήσει»
-
«Η εξωγήινη απάτη»: Κορυφαίος Αμερικανός εξορκιστής προειδοποιεί ότι οι «εξωγήινοι» είναι μεταμφιεσμένοι δαίμονες
-
Μ.Καρυστιανού για Α.Τσίπρα: «Είναι σαν ξαναζεσταμένο φαγητό – Περισσότερο θέαμα παρά ουσία»
-
Δείτε βίντεο: Εκκωφαντική η έκρηξη του βαλλιστικού πυραύλου Iskander-M που ισοπέδωσε κτίριο στο κέντρο του Κιέβου
-
Γ.Ντάβλας για Γ.Μυλωνάκη: «Είναι καλύτερα – Επικοινωνούμε καθημερινά»
-
Ισραηλινά F-16 βομβάρδισαν το νοσοκομείο Τζαμπάλ Αμέλ στην Τύρο – Τέσσερις νεκροί και 127 τραυματίες
-
Κύπρος: Άνδρας εντόπισε τεράστια οχιά μέσα στο φίλτρο της πισίνας του! – Δείτε εικόνες
-
Ρόζαμουντ Πάικ: Η ηθοποιός τα «έψαλλε» με…το γάντι σε θεατή που έστελνε μηνύματα σε παράστασή της – Δείτε βίντεο
-
Porsche 911: Μα 300 χιλιάρικα για μετατροπή σε shooting brake;